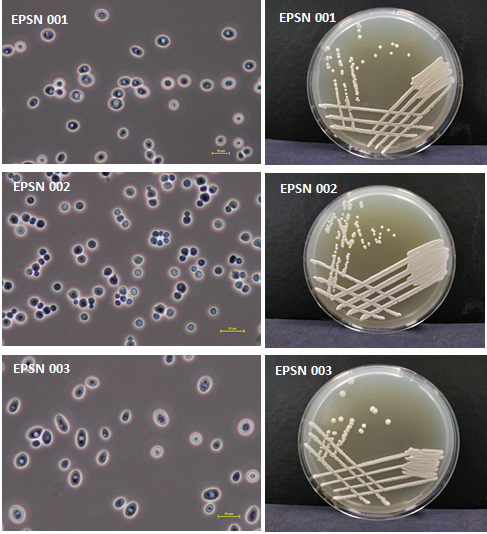

Aktivita III - Podpůrné enologické preparáty ze sekundárních surovin potravinářského průmyslu
Cílem třetí etapy bylo ověření výroby enologických preparátů a jejich následná aplikace v reálných podmínkách. Výroba preparátů se uskutečnila ve čtvrtprovozním měřítku v biotechnologické hale CVMB (Centrum Výzkumu Mikrobiální Biomasy) společnosti EPS biotechnology. Tyto preparáty byly následně využity během fermentace moštu odrůd Hibernal a Chardonnay v experimentálním sklepě EPS biotechnology a pro výrobu Sauvignonu ve vinařství Lahofer a.s. V rámci projektové realizace bylo dosaženo přípravy a použití tří různých enologických preparátů, které se liší způsobem aplikace během vinifikačního procesu a podpory vinifikace v různých fázích procesu:
i) inaktivní kvasinky k rehydrataci aktivních kvasinek;
ii) lyzáty jako výživa během kvašení a ochrana aroma;
iii) buněčné stěny k detoxikaci moštu, jak znázorňuje Obrázek 6.
Uplatnění enologických preparátů je mířeno na střední vinaře, kteří si již objednávají produkt Vlastní kvasinka, který je založený na izolaci autochtonní mikroflóry z vinohradu, následné namnožení kvasinky v reaktoru a dodání ve formě lyofilizovaného preparátu. Množství vyrobené kvasinky Saccharomyces cerevisie je dána objemem reaktoru a přebývající množství lze přeměnit na podpůrné enologické preparáty. Výroba a použití zohledňuje zodpovědný přístup k potravinářství s ohledem na principy cirkulární ekonomie a bezodpadového hospodářství. Enologické preparáty pro Vlastní kvasinku jsou jedinečným produktem na trhu, který posiluje terroir vína a dodává mu svůj unikátní charakter.